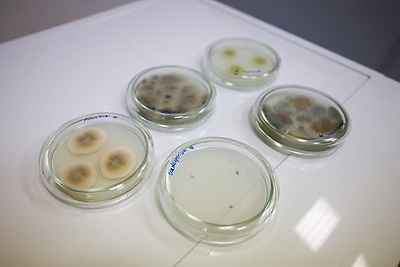
Ночные экскурсии и мастер-классы по каллиграфии: как встретили \"Библионочь\" в Национальной библиотеке Беларуси

Saturday, 25 April 2026г.
Главная >
Ночные экскурсии и мастер-классы по каллиграфии: как встретили "Библионочь" в Национальной библиотеке Беларуси

|
|

Описание
Республиканская акция "Библионочь-2026", приуроченная ко Всемирному дню книги и авторского права, 24 апреля традиционно встретила любителей чтения в Национальной библиотеке Беларуси. Здесь их ждали десятки тематических площадок: лекции, мастер-классы, экскурсии, творческие встречи, игры для детей и взрослых и другие познавательные развлечения. В 2026 году в "Библионочи" приняло участие рекордное количество библиотек - 149. В Национальной библиотеке главными темами акции стали Год белорусской женщины и 20-летие нового здания библиотеки, которое отметят в июне. На снимке: во время мероприятия. Фото Андрея Синявского, БЕЛТА.